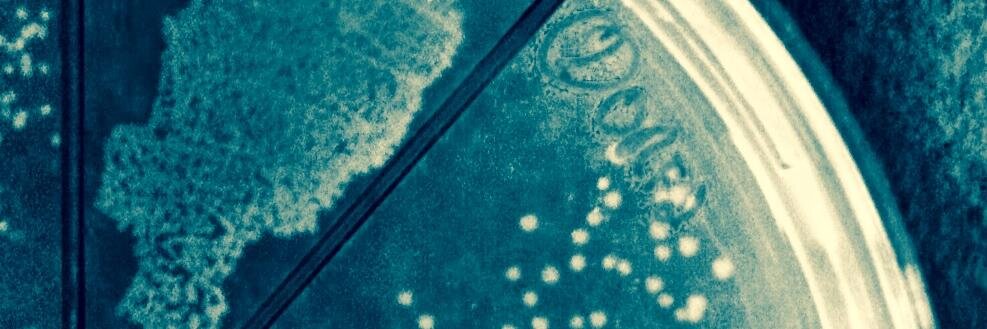
Eric Young banner

Excited that my collaboration with Sue Roberts is now published!! Our awesome student Cassandra used crispr to epigenetically modify Taxus plant cell lines! She focused on repressing phenylpropanoid biosynthesis to boost paclitaxel production.
frontiersin.org/articles/10.33…
English